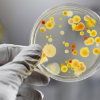

Роспотребнадзор
Вниманию туристов, имеющих договорные отношения с туроператором ООО «ТЕРРА» («Ted Travel»)!
Август 26, 2017 - 08:52 — редакторВ связи с появлением на официальном сайте ООО «ТЕРРА» (туристический бренд TED Travel) сведений о невозможности данным туроператором исполнять свои обязательства перед туристами и заказчиками по договорам реализации туристского продукта, а также появившейся информации об убытках, которые несут туристы, Роспотребнадзор доводит до сведения потребителей рекомендации по получению экстренной помощи и возмещению убытков.
Роспортебнадзор: Как защититься от жары?
Август 19, 2017 - 10:03 — редакторФедеральная служба по надзору в сфере защиты прав потребителей и благополучия человека отмечает, что в ряде регионов Российской Федерации установилась аномально жаркая погода, при которой температура воздуха превышает средние многолетние значения для данного периода года.
Роспотребнадзор предупредил об опасности лихорадки Денге во Вьетнаме
Август 19, 2017 - 09:29 — редакторФедеральная служба по надзору в сфере защиты прав потребителей и благополучия человека информирует, что в странах тропического и субтропического климата в течение последних лет продолжается эпидемиологическое неблагополучие по лихорадке Денге.
Роспотребнадзор разъясняет: о правах потребителей, связанных с расторжением договора о реализации туристского продукта, ввиду угрозы здоровью туристов в Турецкой Республике
Август 15, 2017 - 10:42 — редакторО правах потребителей, связанных с расторжением договора о реализации туристского продукта, ввиду угрозы здоровью туристов в Турецкой Республике.
Роспотребнадзор: Памятка по профилактике вируса Коксаки для туристов
Август 13, 2017 - 05:32 — редакторРоспотребнадзор: Об официальном ответе Министерства здравоохранения Турции по ситуации с вирусом Коксаки
Август 13, 2017 - 05:23 — редакторФедеральная служба по надзору в сфере защиты прав потребителей и благополучия человека сообщает, что получен ответ на запрос службы от Ведомства народного здравоохранения Министерства здравоохранения Турции по эпидемиологической ситуации в провинции Анталья.
Об угрозе безопасности здоровью потребителей туристских услуг, выезжающих на отдых либо находящихся на отдыхе в Турецкой Республике
Август 12, 2017 - 08:58 — редакторВ связи с информацией об участившихся случаях заражения энтеровирусной инфекцией граждан, находящихся на отдыхе в Турецкой Республике, Федеральная служба по надзору в сфере защиты прав потребителей и благополучия человека сообщает.
О приеме обращений от пострадавших после посещения Турецкой Республики
Август 9, 2017 - 08:31 — редакторФедеральная служба по надзору в сфере защиты прав потребителей и благополучия человека в связи с сообщениями об ухудшении эпидситуации по энтеровирусной инфекции на курортах Турецкой Республики сообщает.
Об эпидемиологической ситуации по холере в Кении, Йемене и Судане
Июль 22, 2017 - 09:32 — редакторФедеральная служба по надзору в сфере защиты прав потребителей и благополучия человека продолжает мониторинг заболеваемости холерой в мире и информирует об осложнении эпидемиологической ситуации в Кении, где отмечается рост кишечных заболеваний, в том числе холеры, где на середину июля текущего года зарегистрировано свыше 1 тыс. больных холерой в пяти округах страны.
Что можно требовать от авиаперевозчика при задержке рейса?
Июль 4, 2017 - 10:18 — adminВ связи c произошедшими задержками авиарейсов Федеральная служба по надзору в сфере защиты прав потребителей и благополучия человека разъясняет законодательные аспекты обеспечения защиты прав пострадавших пассажиров.
- « первая
- ‹ предыдущая
- …
- 6
- 7
- 8
- 9
- 10
- 11
- 12
- 13
- 14
- …
- следующая ›
- последняя »